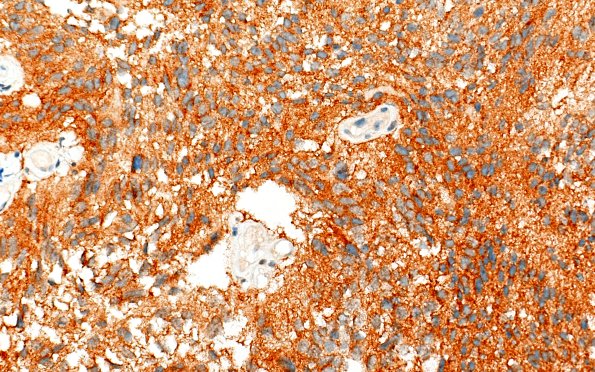
22F1 PXA (Case 22) SYN B1 40X 2

Table of Contents
Washington University Experience | NEOPLASMS (GLIAL) | Pleomorphic Xanthoastrocytoma (PXA) | 22F1 PXA (Case 22) SYN B1 40X 2
22F1,2 There is marked variation in tumor immunoreactivity for the neuronal marker synaptophysin. (SYN IHC)